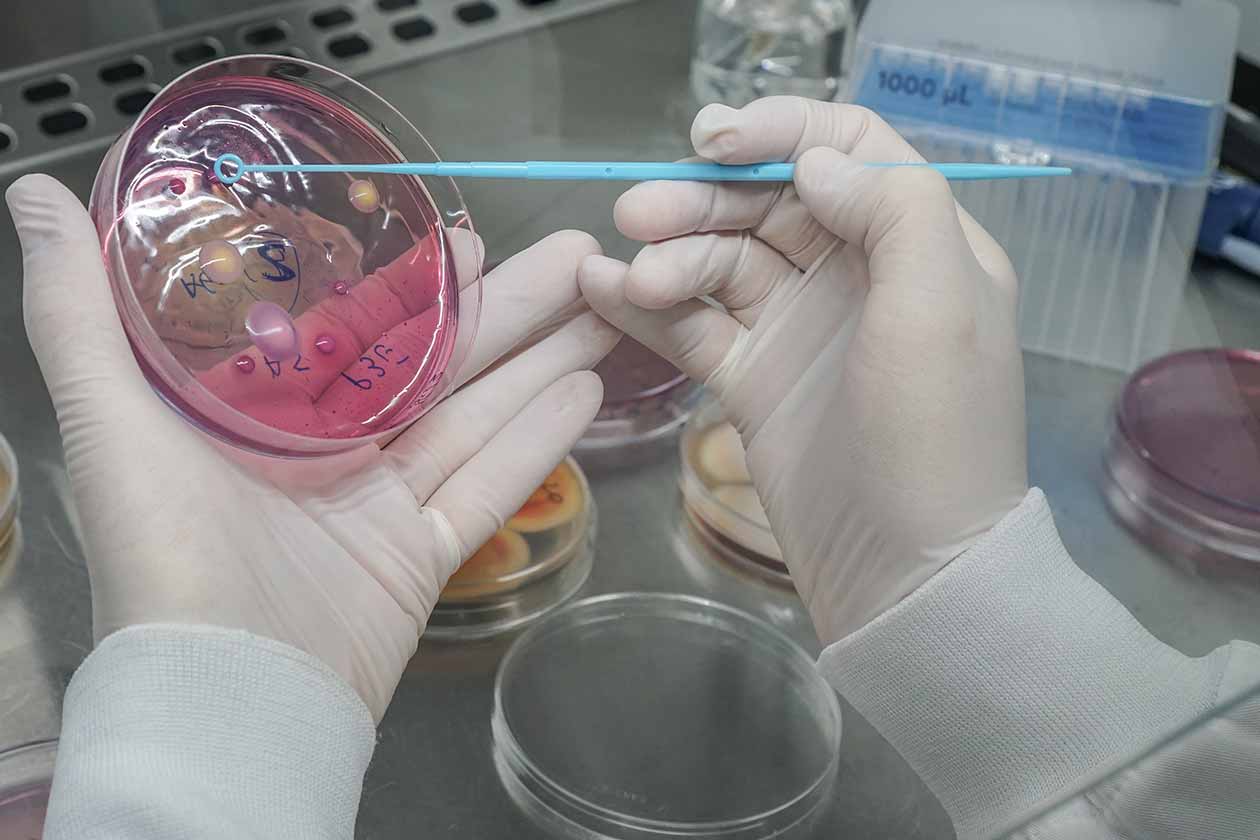

Con el fin de atenuar la aparición y propagación de la resistencia a los antimicrobianos e impulsar el desarrollo y la disponibilidad de nuevos antibióticos eficaces, la Unión Europea lleva años trabajando en una estrategia comunitaria. Un plan de acción en el que la colaboración de todas las partes interesadas, incluidos la industria, la sociedad civil, el mundo académico y los expertos es fundamental. Junto con la industria hemos trabajado en un proyecto en el que investigamos y desarrollamos nuevas estrategias antimicrobianas frente a los patógenos zoonóticos más comunes en la industria alimentaria y en la industria ganadera. De los resultados de este proyecto hablaremos en el webinar que hemos organizado para el 20 de junio: “Herramientas biotecnológicas con potencial antimicrobiano: alternativas al uso de antibióticos en la industria agroalimentaria.
Las enfermedades transmitidas por los alimentos han sido un problema para la sociedad desde el origen de la humanidad. Los tipos, severidad y los impactos de estas enfermedades han cambiado a través de los siglos y de la región pero, a día de hoy, siguen siendo, en mayor o menor medida, un riesgo para la salud de las personas y tienen un impacto muy importante en los sistemas sanitarios de todo el mundo.
Las enfermedades transmitidas por los alimentos suelen ser de naturaleza infecciosa o tóxica y son causadas por bacterias, virus, parásitos o sustancias químicas que ingresan al cuerpo a través de alimentos o agua contaminados. Aproximadamente dos terceras partes de las enfermedades transmitidas por alimentos son causadas por bacterias transmitidas por los alimentos en todo el mundo, con un alto porcentaje de incidencia en los países en desarrollo.
Los animales destinados a la alimentación son los principales reservorios de muchos patógenos bacterianos zoonóticos transmitidos por los alimentos, y los productos alimenticios de origen animal son los principales vehículos de transmisión. La carne, los productos lácteos y los huevos son las principales formas por las que las personas pueden llegar a estar expuestas a bacterias zoonóticas.
Actualmente, la aparición de bacterias zoonóticas multirresistentes asociadas al consumo de productos animales contaminados es una gran preocupación para la salud pública ya que hacen que las principales estrategias antimicrobianas basadas en antibióticos no sean efectivas.
«Una sola salud»: Plan de Acción de la UE para la lucha contra la resistencia a los antimicrobianos y el desarrollo de nuevos antibióticos eficaces
En 2017 la Unión Europea estimaba que las bacterias multirresistentes eran la causa del fallecimiento de 25.000 ciudadanos de la UE, calculándose que en 2050 la resistencia a los antimicrobianos pueda causar más muertes que el cáncer. La Unión Europea inició su estrategia comunitaria en 2001, habiendo avanzado desde entonces, destacando sobre todo el enfoque «Una sola salud». El plan proporciona un marco para medidas continuas y de mayor alcance con el fin de atenuar la aparición y propagación de la resistencia a los antimicrobianos e impulsar el desarrollo y la disponibilidad de nuevos antibióticos eficaces dentro y fuera de la UE.
Como indica la Comisión en la Comunicación 2017/0339, es consciente de que las acciones contra la resistencia a los antimicrobianos no pueden tener éxito sin la colaboración permanente de todas las partes interesadas, incluidos la industria, la sociedad civil, el mundo académico y los expertos no gubernamentales. De conformidad con la COM/2017/0339 el Plan de Acción «Una sola salud» no solo pretende potenciar la investigación, sino también continuar incentivando la innovación, aportar una valiosa contribución a las políticas diseñadas sobre una base científica y a las medidas jurídicas para la lucha contra la resistencia a los antimicrobianos, y colmar las lagunas de conocimiento, como el papel de la resistencia a los antimicrobianos en el medioambiente.
En este contexto, es necesaria la participación de la industria en proyectos cuyo objetivo sea investigar y desarrollar nuevas estrategias antimicrobianas frente a los patógenos zoonóticos más comunes en la industria alimentaria y en la industria ganadera.
Desarrollo de nuevos ingredientes activos con actividad antimicrobiana frente a patógenos en alimentos
En esa línea, desde AINIA hemos estado trabajando entre 2021 y 2022 en el Proyecto MICROBIOSAFE. El objetivo general del proyecto ha sido investigar y desarrollar experimentalmente nuevos ingredientes activos con actividad antimicrobiana frente a patógenos que aparecen en la cadena de producción de alimentos y cuyo origen está asociado a los animales de producción (patógenos zoonóticos).
Los patógenos diana seleccionados en el marco del proyecto MICROBIOSAFE son algunos de los más importantes desde el punto de vista de seguridad alimentaria. En concreto se trabajará para desarrollar estrategias antimicrobianas específicas y que minimicen la generación de resistencias enfocadas a los siguientes patógenos: Salmonella, E. coli, S.aureus, P.aeruginosa, L.monocytogenes y Campylobacter.
Webinar 20 de junio: “Herramientas biotecnológicas con potencial antimicrobiano: alternativas al uso de antibióticos en la industria agroalimentaria”
Teniendo en cuenta los resultados del proyecto, desde AINIA hemos lanzado el WEBINAR “Herramientas biotecnológicas con potencial antimicrobiano: alternativas al uso de antibióticos en la industria agroalimentaria” para el próximo 20 de junio. Este webinar ofrecerá a las empresas nuevos conocimientos sobre nuevos compuestos antimicrobianos biobasados (obtenidos a partir de microorganismos o por vía enzimática) más selectivos, que requieran una menor dosis de aplicación y que permitan generar una menor resistencia a los biocidas tradicionales.
Esta alternativa a los antimicrobianos químicos (conservantes) y a los antibióticos tradicionales supondrán oportunidades de negocio tanto para las empresas de ingredientes como para las empresas del sector ganadero, así como a las empresas que comercialicen productos de higiene industrial.